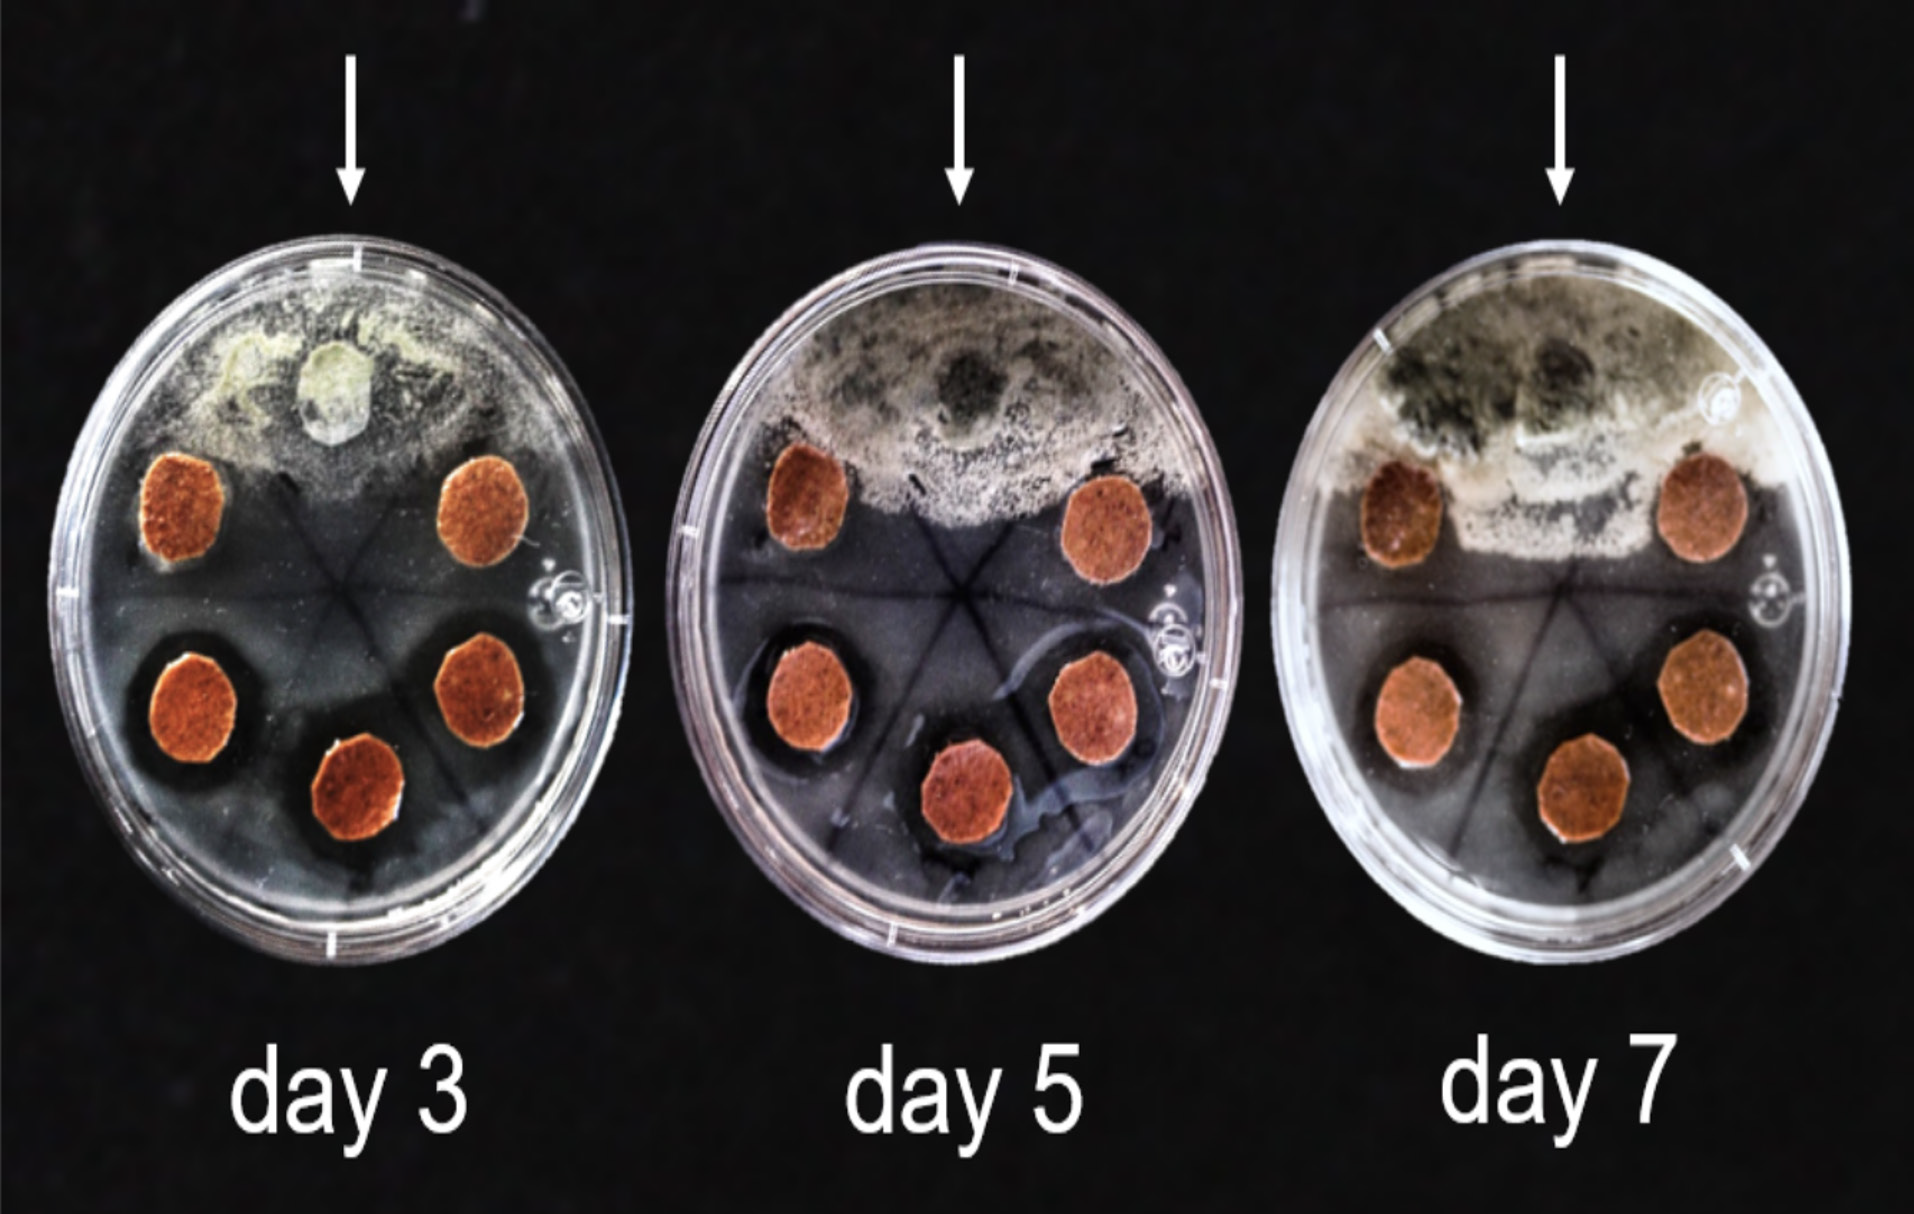

Introduction
In March 2020, like many other universities worldwide, Universidad Autónoma Metropolitana (UAM) closed its doors due to the COVID-19 outbreak. One of the major challenges of transitioning to an online learning system was modifying the laboratory sessions.
Our experience is contextualized in the educational approach at UAM campus Cuajimalpa (UAMC), which follows a constructivist model in which students are encouraged to “develop the skills to learn and think critically to solve problems” (García Franco, 2015). Students must enroll in a mandatory practicum course in the last semester and develop original research to achieve the degree in Biological Engineering. The project comprises a trimester of literature review and project design followed by a trimester of experimentation, results analysis, and writing a short thesis, and it aims for the student to know the field of scientific research, development, or application of biological technologies (Plan de estudios IB, 2017). This involves combining previously acquired knowledge from the curriculum with new one to solve a problem in biochemistry, biotechnology, biomaterials, biomedicine, among other areas. The current biochemistry curricula focus on essential concepts and significant contexts such as the environment, technology, materials, and medicine. To achieve this, various pedagogical activities are used, including exploration, inquiry, modeling, and projects that aim to provide the students with comprehensive knowledge and deepen their understanding and application of chemistry in practical, every day, and industrial situations (Caamaño, 2018).
Different challenges are faced while teaching applied biochemistry within the Biological Engineering degree. Biochemistry integrates the principles and techniques of both chemistry and biology to study the chemical processes that occur within living organisms and the control of biological processes. Teaching and learning in science education are improved and enriched through interdisciplinary approaches within chemistry to facilitate a deep understanding (Ramos Mejía et al., 2023). In engineering, biochemistry plays a vital role in industrial development; consequently, teaching practical, technical, and applied biochemistry is significant (Káš, 1992).
Experiments are effective for research and meaningful learning in which the student can assimilate new knowledge using prior contents, experiences, and motivation (Berrio, 2009). Likewise, experimental activities in education enable students not only to understand the theories in physical sciences and learn but also “to do” and “learn to do.” By integrating procedural knowledge with practical approaches, projects facilitate skill acquisition and foster student initiative and autonomy (Séré, 2002). Projects focus on context-based learning leading to higher-order thinking skills and transferring between the chemistry understanding levels (Avargil, Herscovitz, & Dori, 2012; Avargil, 2019) and its correlation to other disciplines.
Many of the practicum projects in the engineering curricula at UAMC are experimental; therefore, lab sessions are vital. However, due to the campus closure, the experimental projects had to be changed to theoretical approaches, denying the students the opportunity to practice the skills they acquired throughout their careers experimentally. This situation showed that creating teaching and learning spaces for distance education and hybrid modalities is necessary to achieve good scientific literacy (Carrascosa et al., 2006; Ramos Mejía, 2021).
Rather than switching to non-experimental projects, hands-on approaches were implemented to allow students to do practical activities. The synergy of extended laboratory classes in a digital environment increases the likelihood of generating learning and develop attitudes (Selco, 2020; Idoyaga et al., 2021).
Thanks to the mild and non-toxic conditions in which bioplastics are produced, designing and developing projects within materials biochemistry was possible. The problem was identified, research was done, and the objectives and goals were established. All the experiments were adapted to a home kitchen, and the reagents were replaced with chemicals available in drugstores or local supermarkets, while laboratory equipment was substituted with kitchenware and kitchen appliances.
This contribution demonstrates the success of conducting a home-based experimental project, offering flexibility and hands-on learning opportunities. The approach can be the base of remote teaching approaches and benefit universities with limited lab resources to extend biochemistry teaching from theoretical to technical application. It can also benefit students in remote areas without access to labs and working students with limited access to on-campus education. Additionally, it can provide a way to overcome educational barriers for individuals facing gender-based inequalities promoting inclusivity and lifelong learning.
Approach
For this work, the student enrolled in the practicum course was presented with the problem and basic information on the topic. The project underwent weekly supervision through video conferences where instructors encouraged brainstorming, inquiry, and reflection. WhatsApp Messenger was used for direct communication. The student received feedback and recommendations and provided updates through periodical written reports.
With the availability of kitchen, drugstore, and other retailer’s materials, some experiments were designed to offer a safe hands-on approach (see supplementary information). The student identified avocado seed residue as a raw material for bioplastics. To integrate the underlying biochemistry for materials design, three different commercial essential oils were added due to their antifungal potential against common food spoilage fungus (Ribeiro-Santos et al., 2017). The oils reduced the water permeability of the hydrophilic films (Atarés & Chiralt, 2016).
Tutors’ reflection
Two faculty professors guided the student throughout the practicum project. A brief reflection of the academics on the feasibility of the practicum project’s development at home based on the extent of the experimental results, the student´s performance, the limitations, the advantages, and the robustness of the procedure is presented.
Results
Four different films were obtained: one without essential oils (WO), and three with either cinnamon (CI), thyme (TH), or clove (CL) essential oil (Fig. 1). The films had colors ranging from light brown to orange, were flexible and had a granular texture due to the incorporation of the avocado seed flour.
The average thickness of the bioplastics is summarized in Table 1, it ranged from 0.5 mm for the control bioplastic sample without additive to around 1.00 mm for the film with thyme essential oil.
Table 1 Properties of the bioplastics.
| Parameter | WO | CI | CL | TH |
| Thickness (mm) | 0.519±0.129 | 0.746±0.319 | 0.643±0.311 | 1.001±0.238 |
| Contact angle (º) | 35.802±1.909 | 61.223±5.526 | 68.216±8.802 | 42.822±11.043 |
The best-performing films contained cinnamon and clove essential oils, with wetting angles above 60° compared to films without additives with contact angles around 35º (Table 1, Fig. 2).
Table 2 shows the inhibition zone diameters in the disc diffusion assay obtained with the films with the additive from 3 to 7 days. All the films containing essential oils were effective against fungal growth without significant differences between the types of oil used (p>0.05). The antifungal activity was generally maintained throughout the experiment, as pictured in Fig. 3. The filter paper with ketoconazole failed to inhibit fungus growth.
Table 2 Antifungal activity of the bioplastics.
| Grow inhibition halo diameter (mm) | |||
| Film | 3 days | 5 days | 7 days |
| CI | 24±3 | 23±3 | 22±3 |
| CL | 24±2 | 20±1 | 19±1 |
| TH | 25±3 | 22±3 | 19±3 |
Discussion
Petroleum-based plastics play an important role in every field of human activity: from vehicle parts to food packaging. Annual production of these plastics exceeded 300 million tons in 2015, and is estimated to keep rising (Marichelvam et al., 2019). However, this demand carries along some issues. Using petroleum as a raw material has become unsustainable (Ismail et al., 2016). Furthermore, the durability of plastic has led to its accumulation (Shafqat et al., 2021). According to Xanthos & Walker (2017), plastic debris accounts for 60-80% of marine litter. The large pieces of plastic harm marine animals through entanglements, while microplastics, small particles of less than 5 millimeters, have been detected in the gastrointestinal tract of aquatic animals, and even in human placenta (Ragusa et al., 2021; Xanthos & Walker, 2017). Therefore, the development of bioplastics from agro-industrial residues such as avocado seed is significant.
From the four obtained films, one without essential oils (WO), and three with an additive, either cinnamon (CI), thyme (TH), or clove (CL) essential oil, the films without additive had a barely perceptible vinegary smell, whereas those containing essential oils had a penetrating smell, especially the one with cinnamon essential oil, as cinnamaldehyde emits a pungent odor (Gende et al., 2008; National Center for Biotechnological Information, 2021).
There was a slight increase (not significant, p>0.05) in the thickness of the films with the additives due to the low miscibility of the oils in the hydrophilic matrix, which creates an irregular surface (Acosta et al., 2016; Aterés & Chiralt, 2016). The absence of an emulsifier and the oil composition can explain the hydrophilic behavior of the films with additives (Aterés & Chiralt, 2016; Sharma et al., 2021). Adding essential oils improved the moisture barrier properties (p<0.05). The film reinforced with thyme essential oil acted as a poorer moisture barrier than CL and CI because of an uneven dispersion of the oil phase. The main components (>75% w/w) of cinnamon and clove essential oils are cinnamaldehyde and eugenol, respectively (Gende et al., 2008; Gökalp, 2016) whose polar moiety might improve a homogenous distribution. Thyme essential oil is composed of terpenoids (57% w/w) and terpenes (38% w/w) (Shabnum & Wagay, 2011) that lower the solubility in water, leading to the visualization of oil traces in the surface of the films (Acosta et al., 2016).
Cinnamaldehyde contains an aldehyde group and a conjugated double bond outside the ring that are responsible for the deactivation of enzymes in fungi inhibiting the biosynthesis of ergosterol, which leads to damage of the cell membrane and causes leakage of intracellular ions.
Cinnamaldehyde in cinnamon oil is formed by an aldehyde group and a conjugated double bond outside the ring, which are responsible for the deactivation of enzymes in fungi through the biosynthesis of ergosterol present in fungal plasma membranes (Díaz-Galindo et al., 2020). Clove essential oil has an inhibitory effect on growth across various fungal species (Schroder et al., 2017), while thyme essential oil shows antibacterial and antifungal activities due to thymol (23 to 60%) and its phenolic nature (Zhera et al., 2022).
The growth in the filter paper with the antibiotic is attributed to resistance of the fungal species’ to ketoconazole, as this antifungal is ineffective against some aspergillus species, one of the most common molds found on meat (Clark et al., 2012; United States Department of Agriculture, 2005).
Also, the development of synergistic effects of the oils due to the proximity of the discs could contribute to their efficacy (Nazzaro et al., 2017). For example, Nikkah et al. (2016) proved that cinnamon and thyme essential oils exhibit greater antifungal properties when combined.
Tutors´reflection on the biobased plastics project as a remote hands-on approach
In the Biological Engineering program, students develop practicum projects using a constructive learning approach to solve problems. Although many engineering projects can be theoretical, providing the students with options to experiment is important for developing skills and competencies and integrating knowledge from basic sciences desirable for engineering careers. The reported approach shows that developing an experimental practicum project at home with simple and readily available materials is possible while enabling critical thinking, planning, experimental design, and education for sustainable development.
In this work, a problem, namely the need for environmentally friendly materials, was solved in a remote teaching scheme by establishing a project to produce bioplastics with antifungal properties. Through the project, the student could integrate knowledge from previous courses such as sustainability, chemistry, biochemistry, statistics, design and analysis of experiments, and molecular structure of biomaterials, among others (Plan de estudios IB, 2017). The bioplastics were successfully obtained, modified (optimized), and characterized. The addition of the essential oils increased the hydrophobicity of the bioplastics and imparted them with antifungal activity. Due to the virtual teaching conditions, simplified methodologies and a practical and robust approach were adopted compared to conventional laboratory procedures to avoid unit operations such as extraction and purification. The approach differed from laboratory experiments that use harsher chemicals, extraction, and isolating procedures for bioassays, thus requiring stricter controls during manipulation and various steps that increase costs. Herein, friendlier chemicals were used in a practical approach that minimized processing steps. Moreover, less harmful residues are produced. Furthermore, a wild-type microbial consortium was used, closely approaching the real conditions to which food is subjected. The sturdiness of the procedure might make it interesting for cost-efficiency applications in industry.
The characterization was limited to a certain extent due to the lack of specialized equipment. However, the data obtained was enough to provide a good approximation of the behavior of the studied materials. Nonetheless, the results can be analyzed and compared to data obtained with laboratory equipment to estimate the accuracy of the methods giving rise to future optimization projects. Likewise, further research is needed to determine the effectiveness against other microorganisms and the synergistic effect of the combination of essential oils. The moisture-absorption nature of the starch-based bioplastics was also reduced by the addition of the oils, particularly cinnamon and clove, although the use of an emulsifier could have increased the hydrophobicity of the films by enhancing the miscibility of the oils in the casting solution.
It is crucial to emphasize that it is essential for students to have the opportunity to participate in the development of experimental designs instead of simply following detailed instructions provided by the faculty academics. This is particularly relevant given the central role that experimental design plays in research and for students to gain a proper understanding of the relationship between science and technology. The student then has an active participation in the development of experimental designs and the discussion of the relevance of the work, the formulation of hypotheses, the planning of an experimental frame, and the analysis of results. This, in turn, allows for solid bases of scientific and technological knowledge and solves problems closer to the actual applications (Carrascosa et al., 2006).
Furthermore, the educational process should enable the students to build their own concepts and understanding within processes of learning to learn and complement what is being taught, allowing them to choose based on scientific principles and not be limited to simple instruction, training, and memorization that are common in the process of heteroeducation derived just from the teachers (Touriñán-López, 2019). As an experimental hands-on experience, the student was motivated and engaged fully in the project with a higher level of performance involving creativity, organization, and design thinking to adapt experiments, methodologies, and characterization to a home-based scenario. Moreover, through the project, the student developed strong responsibility, leadership, self-confidence, project management and logistics, and decision-making while gaining skills transferable to employment. In this way, the project had an axiological role in helping the student develop values, attitudes, and beliefs (Ramos et al., 2017; Touriñán-López, 2019).
In project-based and problem-solving teaching-learning approaches such as the one presented here, the academics are just a guide and motivate the learning process while providing the flexible platform of a real problem for the student to develop skills while the student had an active role in self-directed learning to acquire new information and prepare for lifelong learning (Travieso-Valdés & Ortíz-Cardenas, 2018).
Reflecting on the current situation in education in countries like Mexico, where the adoption of virtual education lags even after the pandemic due to the continued use of traditional teaching methods, becomes crucial. Utilizing technological advancements to promote educational development and update pedagogical approaches is essential, considering that virtual platforms offer a valuable alternative for education in remote areas (Torres & Rodríguez, 2019). Moreover, despite certain changes in the distribution of household tasks, women continue to bear the primary role of caregiving and domestic responsibilities. This not only represents enduring gender stereotypes but, more significantly, the absence of organizational and structural support within higher education (Bello & Estébanez, 2022). Remote teaching schemes may help to overcome educational barriers for individuals facing gender-based inequalities.
Conclusions
This work proves the feasibility of a home-based and hands-on approach as an alternative to practical laboratory research sessions. It highlights the importance of adopting remote project-based and problem-solving teaching and learning approaches, as illustrated in the case of a practicum project developed in the Biological Engineering program.
The results show that it is possible to adapt to changing circumstances, such as the transition to virtual teaching, and provide quality and equitable educational opportunities.
The experimental approach had some limitations as analytical instruments were not used; however, the results can be used as a proof of concept to develop deeper laboratorybased knowledge in the future and present the opportunity for students to pursue optimization procedures.
This project-based and problem-solving teaching-learning approach allowed the student to integrate knowledge from various scientific areas such as: chemistry, biochemistry, statistics, design and analysis of experiments, and molecular structure of biomaterials, among others within the reach of engineering. Furthermore, even though framed in a remote teaching model, this extended laboratory scheme, helped the student to develop interdisciplinary skills, competencies, and knowledge required for an engineering career while addressing a concrete problem.
In general, in the context of education in Mexico, even after the pandemic, there is a need to harness remote education to overcome educational barriers and update pedagogical approaches as traditional teaching methods persist. However, to get a better understanding and instruction for both face-to-face and remote teaching, it is rather critical that students actively participate in their education. Project-based teaching promotes active learning and allows great involvement of the students in hypothesis formulation, experiment planning, and results analysis in trying to solve a problem rather than simply following detailed instructions.
Additionally, it is important to mention that flexible teaching strategies presented in this work, in which the opportunity to experiment exists without the constraint of geographical boundaries, can be applied to universities with limited laboratory resources and to address gender inequalities in education.











 nueva página del texto (beta)
nueva página del texto (beta)